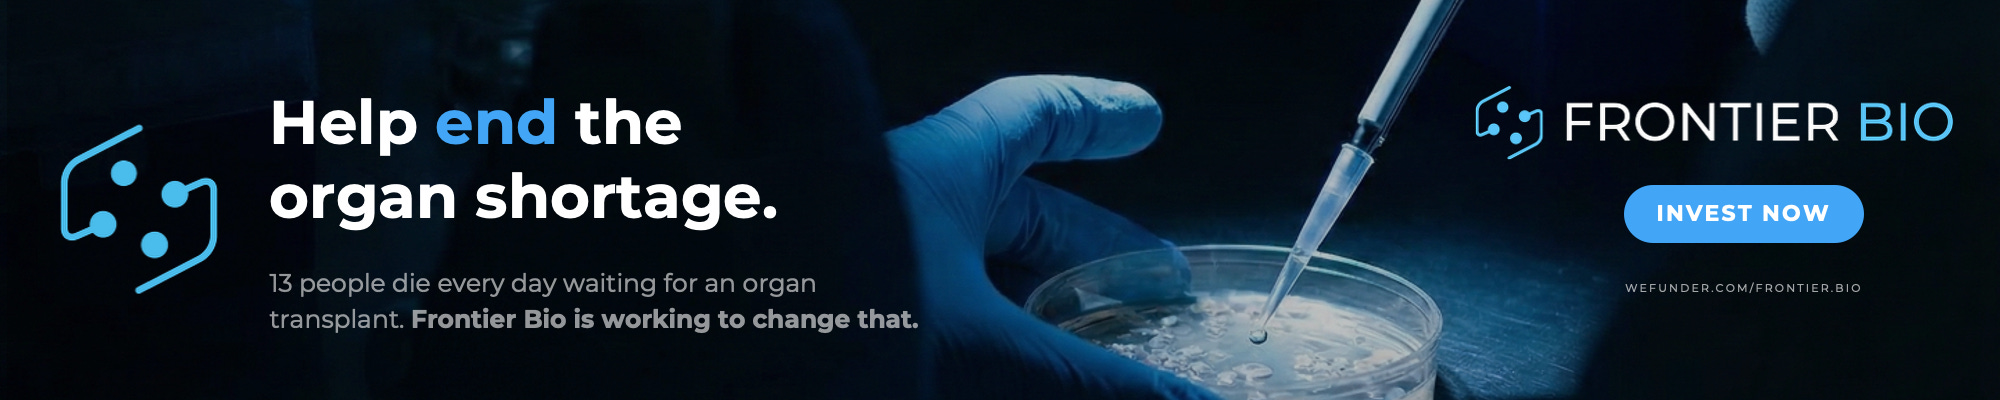

PurposeBuilt100™ in the Boston Herald, New Impact Offerings, Empowering Young Professionals, Rethinking Risky ‘Safe’ Portfolios, and Accelerating Capital for Purpose-Driven Businesses!
This week highlights PurposeBuilt100™ in the spotlight, new impact offerings, career innovation, smarter investing, and accelerated capital for purpose-driven ventures.
Superpowers for Good should not be considered investment advice. Seek counsel before making investment decisions. When you purchase an item, launch a campaign or create an investment account after clicking a link here, we may earn a fee. Engage to support our work.
You can advertise in Superpowers for Good. Click to learn more about our affordable options.
Featured in the Boston Herald: PurposeBuilt100™ Launches to Spotlight America’s Fastest-Growing Purpose-Driven Companies
PurposeBuilt100™—a new national recognition program from The Super Crowd, Inc. (a public benefit corporation)—is now accepting applications to identify and rank the 100 fastest-growing purpose-driven companies in America. Built on the idea that capital flows to companies proving both mission and measurable performance, the ranking uses verified five-year revenue growth (2021–2025) to signal credibility, traction, and trust to investors, customers, partners, and top talent. Apply now: https://PurposeBuilt100.com
NOVICA Featured Among New Impact Offerings - March 23, 2026
Each week, Superpowers for Good shares a list of all the new investment offerings added to FINRA-registered crowdfunding portals and by broker-dealers. We focus on and list first those with social impact and underrepresented founders. We also add other newly launched offerings that may be of interest to our community. We’ll share four separate lists:
Impact offerings determined by our proprietary analysis.
Offerings with minority founders.
Deals with women founders.
Other new offerings added during the week.
Sometimes, it takes weeks for our source to determine that a company has a social impact, a woman, or a minority founder. When we discover an offering qualifies for our list, even if it is no longer new, we will include it. See the lists below.
Helping Young Professionals Build Careers: Inside Deepak Bhootra’s RISEUP@work Platform
tl;dr:
Deepak Bhootra shares his vision for RISEUP@work, a platform to guide young professionals.
He highlights how career development is now a personal responsibility rather than an employer priority.
RISEUP@work offers tools, coaching, and a community to help users avoid mistakes and grow.
Deepak explains his empathy-driven mentorship philosophy, helping others rise to their potential.
The episode concludes with details on RISEUP@work’s crowdfunding campaign and how to get involved.
When ‘Safe’ Feels Risky: Rethinking Portfolios in an Unstable World
A lot has happened in the past 28 days, since I wrote: “Preparing for the Next Bear Market—Using, Not Avoiding, Regulated Investment Crowdfunding.”
The Dow Jones Industrial Average has fallen 6.7%.
On a $100,000 portfolio, that’s a $6,700 decline.
That’s not theoretical. That’s real money—gone in a month.
And yet, we continue to describe public equities as “safe.”
They aren’t. They are familiar.
The Shock We Didn’t Price In
What triggered the recent decline?
Not earnings reports.
Not interest rate changes.
Not a predictable economic indicator.
Instead, markets reacted to geopolitical conflict—specifically, a sudden and surprising war with Iran and the growing risk of extended regional instability.
And here’s the uncomfortable truth:
Conflicts like this are rarely resolved as quickly as leaders promise.
We’ve seen this before. Wars that begin with expectations of swift resolution often stretch into years. Sometimes decades. The ripple effects—especially when energy infrastructure, shipping lanes, or regional alliances are involved—can reshape the global economy in ways few anticipate at the outset.
For investors, that introduces a category of risk that is both profound and unavoidable.
PurposeBuilt100™ Is Our Boldest Initiative Yet to Help Capital Flow Faster to Purpose-Driven Businesses
Most of our work has one goal: helping more capital flow to businesses that are building really social and environmental value.
That has guided the work we do at Superpowers for Good and across the broader SuperCrowd ecosystem for years. We feature founders. We spotlight offerings. We host live pitches. We educate investors. We build community among entrepreneurs, investors, judges, advisors, and ecosystem builders. In our 2025 Impact Report, we estimated that this work helped catalyze roughly $500,000 in capital while reaching thousands through education and featuring 69 issuers across the year.
But as important as all of that is, I’ve come to believe something even more strongly:
Founders do not need more noise. They need more credibility.
Capital rarely moves on inspiration alone. It moves when investors, partners, customers, and other market participants see a company as real, growing, disciplined, and worth believing in. That is especially true for purpose-driven companies. Too often, they are asked to prove not only that their mission matters, but that their businesses are durable, scalable, and investable.
That is why we created PurposeBuilt100™.
PurposeBuilt100™ is designed to recognize the 100 fastest-growing purpose-driven companies in America through a disciplined review of five-year revenue growth. It is not a popularity contest. It is not a vague “good company” award. It is designed to become a meaningful market signal—one that says this company is building with purpose and proving it with growth.
Unlocking Capital for Entrepreneurs: Insights from Tyrus Shivers
tl;dr:
Tyrus Shivers explains how Legacy Wealth Capital Group helps entrepreneurs scale and secure funding.
He highlights the importance of building “investable, bankable, and scalable” business structures.
Tyrus discusses how Regulation Crowdfunding (Reg CF) creates capital opportunities for underserved founders.
He shares his mission to empower minority communities to build generational wealth through entrepreneurship.
Tyrus reveals his superpower: simplifying complexity to help others take meaningful, actionable steps.
Devin Thorpe Featured on The TAGLine Podcast (Powered by The Aebli Group): The Blueprint for Impact Investing—Resilience, Returns & the Future of Crowdfunding
Forget everything you think you know about crowdfunding. Justin Starbird sits down with Devin Thorpe—founder of Superpowers for Good and former Forbes contributor—for a candid conversation on what holds investors back, his practical “two-screen” process for evaluating impact deals (beyond the mission), the one trait he consistently sees in successful founders after interviewing 1,000+, and why recognizing profitable, high-impact companies (including the future of PurposeBuilt100™) matters for growing the market. If you’re a founder considering a Reg CF raise, an investor seeking meaningful returns, or simply curious about democratizing capital, this is a must-listen—press play and hear Devin’s unfiltered take on aligning your values with your wallet.
A Global Voice for Regeneration, Innovation, and Impact
Regeneration Global Magazine is a dynamic digital publication spotlighting solutions, leaders, and ideas advancing a sustainable, regenerative future. Covering topics from ecology and green technology to finance, health, and indigenous wisdom, it connects a global community of changemakers. Co-produced and distributed in partnership with Green2Gold--our partner for SuperGreen Live--the magazine amplifies innovative projects, educates readers, and inspires collaborative action to build resilient economies and restore our planet for future generations.
Discover Vetted Impact Investments in One Place
Explore smarter investing with the SuperCrowd Investment Directory—your go-to resource for discovering vetted impact opportunities. Browse nearly 100 live offerings, including Devin’s Impact Picks, complete with due diligence insights to help you invest with confidence. Start searching, comparing, and uncovering opportunities that align with both your financial goals and your values.
Support Our Sponsors
Our generous sponsors make our work possible, serving impact investors, social entrepreneurs, community builders and diverse founders. Today’s advertisers include Cineblock Films, Frontier Bio, PurposeBuilt100™ Ranking Application, Mission Booster Procurement, and SuperCrowd26 featuring PurposeBuilt100™️. Learn more about advertising with us here.
Max-Impact Members
(We’re grateful for every one of these community champions who make this work possible.)
Brian Christie, Brainsy | Cameron Neil, Lend For Good | Carol Fineagan, Independent Consultant | Hiten Sonpal, RISE Robotics | John Berlet, CORE Tax Deeds, LLC. | Justin Starbird, The Aebli Group | Lory Moore, Lory Moore Law | Marcia Brinton, High Desert Gear | Mark Grimes, Networked Enterprise Development | Matthew Mead, Hempitecture | Michael Pratt, Qnetic | Mike Babbit | Coledger Solutions | Mike Green, Envirosult | Nick Degnan, Unlimit Ventures | Dr. Nicole Paulk, Siren Biotechnology | Paul Lovejoy, Stakeholder Enterprise | Pearl Wright, Global Changemaker | Scott Thorpe, Philanthropist | Sharon Samjitsingh, Health Care Originals
Upcoming SuperCrowd Event Calendar
If a location is not noted, the events below are virtual.
SuperCrowd Impact Member Networking Session: Impact (and, of course, Max-Impact) Members of the SuperCrowd are invited to a private networking session on April 14th at 1:30 PM ET/10:30 AM PT. Mark your calendar. We’ll send private emails to Impact Members with registration details. Upgrade to Impact Membership today!
SuperCrowdHour, April 15, 2026, at 12:00 PM Eastern. Devin Thorpe, CEO and Founder of The Super Crowd, Inc., will lead a session on “Compliance Made Easy: Navigating Form C.” Drawing on his extensive experience as an investment banker, impact investor, and crowdfunding expert, Devin will simplify the complexities of Form C filing for regulated investment crowdfunding campaigns. In this session, he’ll walk through the key components of Form C, highlight common compliance pitfalls, and share practical strategies to ensure your offering meets regulatory requirements with confidence. Whether you’re launching your first campaign or refining your compliance process, this SuperCrowdHour will equip you with the knowledge to navigate Form C efficiently—so you can focus on building trust and raising capital successfully.
SuperCrowd26 featuring PurposeBuilt100™️: This August 25–27, founders, investors, and ecosystem leaders will gather for a three-day, broadcast-quality global experience focused on disciplined capital formation, regulated investment crowdfunding, and purpose-driven growth. We’re bringing together leading voices in impact investing, compliance, digital marketing, and circular economy innovation to deliver practical frameworks, real-world case studies, and actionable strategies. The event culminates in the PurposeBuilt100™️ Showcase, recognizing 100 of the fastest-growing purpose-driven companies in the U.S. Register now to secure your seat and get all the details. August 25–27, streaming worldwide.
Share the application for the PurposeBuilt100™: Purpose-driven founders deserve recognition. The PurposeBuilt100™ application window is now open—celebrating the fastest-growing companies building profit with purpose. If you know a founder creating real impact and real growth, please share this opportunity. Applications are free and confidential. Explore the program and apply today: PurposeBuilt100.com.
Community Event Calendar
Successful Funding with Karl Dakin, Tuesdays at 10:00 AM ET - Click on Events.
Step inside the future of homebuilding at Resilient by Design: Inside the Rebuild Process. Join at Azure Printed Homes in Gardena, CA for an exclusive behind-the-scenes experience featuring live demonstrations of modular construction and 3D printing, expert insights, and a guided factory tour. Enjoy coffee, connect with innovators, and explore homes in progress. Space is limited—secure your spot by registering for the March 28 Morning session, and March 28 Afternoon session or the additional April 12 event today!
Join the RMAIIG Education Subgroup on March 30, 2026 (6:00–7:00 PM) in the Aerospace Building, AERO N240 (3775 Discovery Dr, Boulder, CO) for “Vision to Reality: AI Avatars in Education” with Karl Dakin (Dakin Capital LLC), exploring how multi-avatar AI (CAP, TAM, and “BEN”) can support learning through Socratic dialogue, assessments, and case guidance—free pizza, RSVP here: https://forms.gle/MBj3mCumdtwXWDo29
Platform Leaders Workshops Program – 5th ICAFR (Málaga, April 8–10, 2026): Join GECA and EDFA for hands-on, interactive workshops for crowdfunding platforms and ecosystem builders—covering investor UX & engagement, secondary markets/technology/tokenisation, and platform data & research—plus dedicated peer exchange with global platform leaders. Register: https://www.crowdfunding-research.org/pago
ICW 2026 Keynote Kickoff - Apr 13 | 10:30–11:00 AM PT - Tim Draper kicks off ICW 2026 with insights on backing transformative startups. Set the stage for three days of pitches, panels, and competition.
Creators as an Asset Class - Apr 13 | 11:00–11:55 AM PT - Scott Kitun and Brian Belley explore creator investing as a new asset class. Learn the opportunities, risks, and emerging playbook.
Group A Pitch Session - Apr 13 | 12:00–12:55 PM PT - Devin Thorpe, Hugh McDermott, and Wendel Afonso present live pitches. Vote for the top startup advancing to the Championship.
Group B Pitch Session - Apr 13 | 2:00–2:55 PM PT - Paul Lovejoy, Sona Shah, Joe Schaeppi, and Hiten Sonpal pitch live. Cast your vote and back the strongest founder.
Capital Dept: Diversifying the Capital Stack - Apr 14 | 11:00–11:55 AM PT - Kelley Frank, Brian Belley, Olowo-n’djo Tchala, Yael Weiss, and Wendel Afonso share proven fundraising strategies. Learn how to plan, launch, and close a successful raise.
Group C Pitch Session - Apr 14 | 12:00–12:55 PM PT - Justin Renfro, Franck Lahaye, and Trevor Legwinski feature in this live pitch round. Watch, evaluate, and vote for the standout startup.
The Listing Playbook - Apr 14 | 1:00–1:55 PM PT - Ajay Tandon, Chris Lustrino, and Gregg Jaclin discuss post-raise pathways. Learn how startups prepare for listings and liquidity.
Group D Pitch Session - Apr 14 | 2:00–2:55 PM PT - Chase Collins, Amanda Benaim, Arthur Erickson, Chad McClennan, and Cole Shepherd pitch live. Vote for who advances to the final round.
Beyond Stocks: Alternative Investing - Apr 15 | 11:00–11:55 AM PT - Scott Kitun and Darren Rovell explore collectibles and alternative assets. Discover trends shaping modern portfolios.
Group E Pitch Session - Apr 15 | 12:00–12:55 PM PT - Eitan Charnoff, Teddy Lyons, Annette Azan, Jaeson Bang, and Jeremy McCool present the final pitches. Last chance to vote before finalists are selected.
Compliance & Regulatory Landscape - Apr 15 | 1:00–1:55 PM PT - Brian Belley, Andrew Stephenson, and Jason Fishman cover key regulations. Understand disclosures, protections, and what’s changing.
Championship Pitch & Closing - Apr 15 | 2:00–3:15 PM PT - Chris Lustrino, Léa Bouhelier-Gautreau, and Teddy Lyons host the final round. Watch the winner crowned and ICW 2026 conclude.
Save the Date! October 20th and 21st will be the Crowdfunding Professional Association Regulated Investment Crowdfunding Summit for 2026. This is the event of the year for everyone in the crowdfunding ecosystem.
If you would like to submit an event for us to share with the 10,000+ changemakers, investors and entrepreneurs who are members of the SuperCrowd, click here.